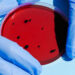
Bacteria Klebsiella Oxytoca: ¿cuáles son sus síntomas?

El mousse navideño es un postre que se ha convertido en un clásico durante las festividades para algunas familias debido a la combinación tanto de sabores como de texturas que ofrece al paladar, además de que resulta ligero y cremoso.
Gracias a que es posible darle una presentación elegante y a que su sabor se enriquece de diferentes ingredientes, el mousse navideño se ha ganado un lugar especial en las celebraciones familiares porque su preparación es bastante sencilla. Con esto se convirtió en una opción ideal para quienes desean impresionar a sus invitados sin tener la necesidad de pasar horas en la cocina.
A menudo se prepara con ingredientes como chocolate, frutas y especias típicas de la temporada, lo que permite personalizarlo según los gustos de cada familia. Además, su versatilidad permite que se sirva en diferentes formatos, es decir, desde copas individuales hasta grandes porciones.
Receta de mousse navideño

La receta fue publicada por Julio Sarmiento en el sitio web de Recetas Nestlé. Las porciones rinden para cinco personas y cada una aporta 344.5 kcal.
Ingredientes
- 200 g de chocolate negro (aproximadamente 70% de cacao)
- 3 huevos
- 100 g de azúcar
- 1 cucharadita de extracto de vainilla
- 300 ml de crema para batir
- Una pizca de sal
- Opcional: Frutas secas o frescas para decorar (como nueces, almendras, o frambuesas)
Procedimiento
- Derretir el chocolate: comienza derritiendo el chocolate negro a baño maría o en el microondas. Si eliges el microondas, calienta en intervalos de 30 segundos, removiendo entre cada uno, hasta que esté completamente derretido y suave. Deja enfriar un poco.
- Batir los huevos: en un tazón grande, separa las claras de las yemas. Bate las yemas con el azúcar y el extracto de vainilla hasta que la mezcla se vuelva cremosa y pálida. Luego, incorpora el chocolate derretido a esta mezcla, asegurándose de que no esté demasiado caliente para evitar cocinar las yemas.
- Montar las claras: en otro tazón, bate las claras de huevo con una pizca de sal hasta que formen picos firmes. Luego, incorpora suavemente las claras montadas a la mezcla de chocolate con movimientos envolventes para mantener la aireación.
- Incorporar la crema: en un tercer tazón, bate la crema para batir hasta que forme picos suaves. Agrega la crema batida a la mezcla de chocolate y claras, integrando cuidadosamente hasta que todo esté bien combinado.
- Refrigerar y servir: vierte la mezcla en copas individuales o en un recipiente grande y refrigera durante al menos 4 horas, o hasta que esté firme. Antes de servir, puedes decorar con frutas secas o frescas al gusto. ¡Disfruta de tu mousse navideño!
Cuál es el origen del mousse navideño

De acuerdo con el sitio web Excelencias Gourmet, el origen del mousse es un tanto incierto debido a que existen dos teorías. La primera es que lo inventó el afamado pintor postimpresionista Toulouse Lautrec pero se desconoce el origen de esta creencia.
La segunda conjetura es que lo creó el español Manuel Cordero por órdenes del cocinero mayor del ejército VIII francés, en la visita de Napoléon Bonaparte a la campaña de Astorga en 1810, pues le pidió que preparara “su espuma de chocolate”.
El resultado sorprendió tanto al chef que llevó al español ante la corte francesa y a partir de ese momento se popularizó este postre por Europa.
La palabra mousse proviene del francés moss que significa musgo o espuma. La primera aparición del mousse se encuentra en el libro culinario titulado “Les soupers de la cour” de 1755, del cocinero francés Menón, en el que describe un mousse al que se le podía añadir chocolate, café o azafrán.